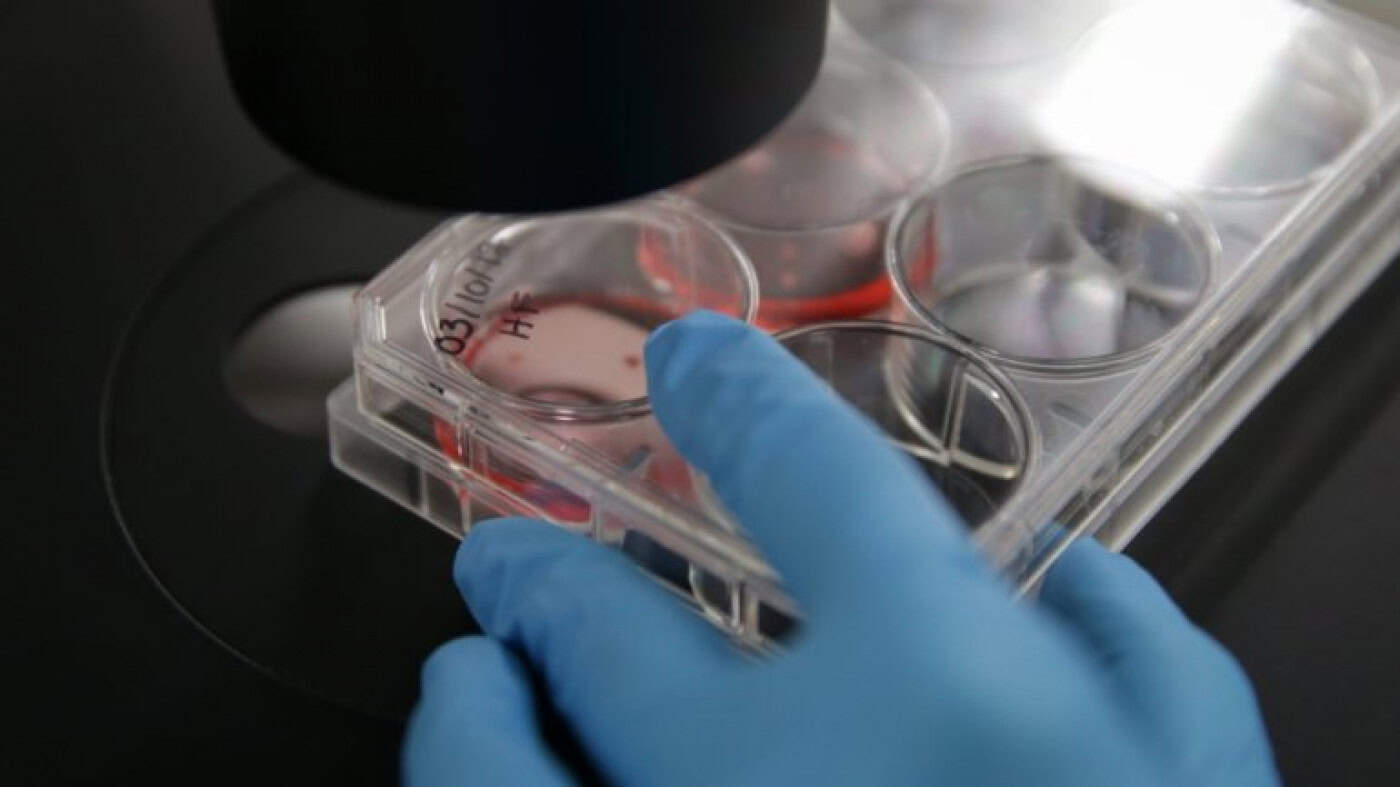
UMinho desenvolve tratamento para o subtipo mais agressivo do cancro da mama

UMinho desenvolve tratamento para o subtipo mais agressivo do cancro da mama
Ainda está em fase pré-clínica, mas os resultados obtidos até agora são animadores. O Instituto das Ciências da Vida e da Saúde da Escola de Medicina da Universidade do Minho tem em curso uma investigação para encontrar um tratamento eficaz para o triplo negativo, o subtipo mais agressivo do cancro da mama.
Esta opção terapêutica, constituída por cromenos sintéticos, uma família de compostos abundantes na natureza, tem mostrado eficácia no combate à doença. Em declarações à RUM, a investigadora responsável pelo projecto explica que, “ o tratamento mostrou ser capaz de regredir o tamanho tumoral”.
“Significa que não deixa avançar o crescimento tumoral. Isso é espectacular porque se trata exactamente daquilo que é pretendido”, acrescenta. No que diz respeito à toxicidade, através dos testes já feitos em animais, também “não foi detectado qualquer efeito adverso”.
Ciente de que “o caminho é bastante longo”, Marta Costa refere que é necessário “continuar a estudar outros parâmetros ligado à eficiacia, mas também, por exemplo, à bio-disponibilidade e a bio-absorção do composto” antes de se chegar à fase clínica.
A propriedade intelectual do projecto, a ser desenvolvido por mais de dez investigadores do Instituto das Ciências da Vida e da Saúde, está já protegida por patente internacional. A investigação recebeu, recentemente, financiamento do Fundo Europeu de Desenvolvimento Regional para a Patente Internacional, também apoiada pela Associação Ciência, Inovação e Saúde.
Ainda assim, a responsável pelo projecto espera que sejam estabelecidas parcerias com a indústria farmacêutica, de forma a que “o processo avance o mais depressa possível”.
Novo tratamento será uma opção mais viável do que a quimioterapia
Neste momento, o procedimento padrão para os pacientes diagnosticados com o subtipo triplo negativo é a quimioterapia. Apesar de reconhecer a importância deste tratamento, sobretudo numa primeira fase, Marta Costa afirma que “não é 100% eficaz”.
“Estes pacientes acabam por voltar a ter, muitas vezes, o cancro de uma forma mais activa e agressiva. Daí existir uma grande necessidade e urgência em encontrar um tratamento mais específico”, complementa.
O facto de o triplo negativo, que representa 15 a 20% de todos os tumores malignos da mama, ser o único subtipo sem um tratamento adequado é explicado por “razões moleculares”.
“Se analisarmos os tecidos, os outros subtipos têm as mesmas características, o mesmo aspecto. Já este apresenta uma variabilidade muito grande, mesmo entre pacientes. É muito difícil haver uma terapia que funcione de forma eficaz”, conclui a especialista em Química Medicinal.
